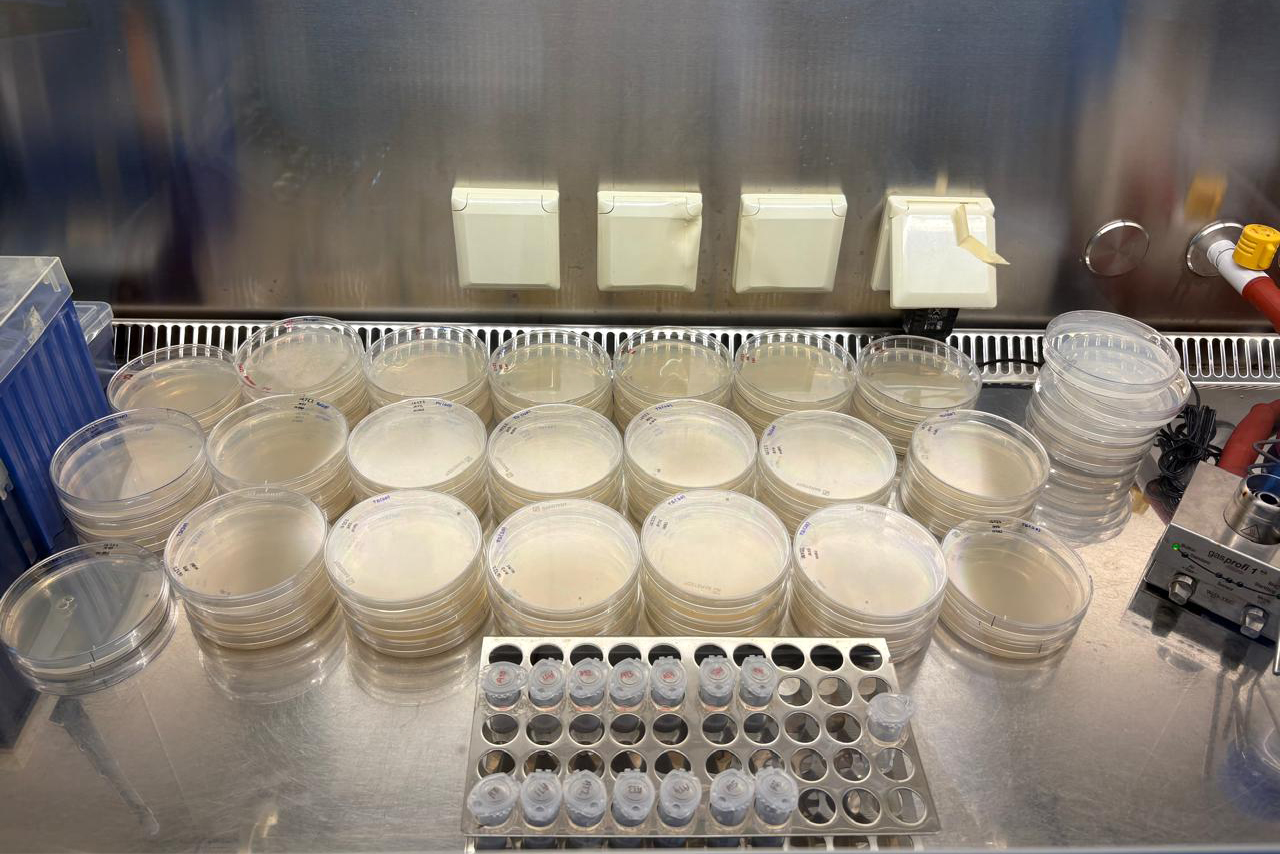

FABI Researchers strengthen Mycobiomics collaborations in Austria and Germany 2025-10-15
As the final part of the Mycobiomics project, supported by the Marie Skłodowska-Curie Actions Research and Innovation Staff Exchanges (MSCA-RISE) grant, FABIans Jenna-Lee Price, Kiara Munsamy and Unathi Tshabala recently completed collaborative research visits to Austria and Germany.
In Austria, Jenna and Kiara spent three months at the Austrian Institute of Technology (AIT) and the University of Natural Resources and Life Sciences (BOKU), respectively. Working together with Dr Markus Gorfer, Jenna established an Agrobacterium-mediated transformation system for Pseudopithomyces toxicarius. At the same time, Kiara explored secondary metabolite production in novel Fusarium species in collaboration with Dr Michael Sulyok and Prof. Joseph Strauss.
Meanwhile, Unathi spent three months at the Helmholtz Centre for Infection Research in Braunschweig, Germany. In collaboration with Prof. Marc Stadler and Dr Christopher Lambert, she characterized secondary metabolite profiles in the genus Pseudopithomyces, contributing to a better understanding of its chemotaxonomy.
These international collaborations mark the conclusion of the Mycobiomics project and support its overarching goal of using -omics technologies to enhance our understanding of fungal biodiversity and uncover novel bioactive compounds with potential applications in biotechnology and agriculture.
The FABI team, led by Dr Neriman Yilmaz and Prof. Cobus Visagie, extend their thanks to their hosts in Austria and Germany for their hospitality and for sharing their expertise and knowledge throughout these productive research exchanges.